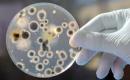
Pelėsio naikinimas-1

ĮKELTI SKELBIMĄ
PRISIJUNGTI
ĮKELTI SKELBIMĄ
PRISIJUNGTI
Pelėsio naikinimas

- Nurodykite sritį:
- Įvairios paslaugos
NAIKINAME PELĖSĮ IR JO ATSIRADIMO PRIEŽASTIS!
"SANLAB" SPECIALISTAI SIŪLO:
▪ Nemokamą vizitą ir apžiūrą;
▪ Nemokamą mikroklimato analizę;
▪ Konsultaciją dėl nustatytų problemų sprendimo būdų;
▪ Darbų atlikimą Jums patogiu metu;
▪ Ekologiškų metodų naudojimą;
▪ Garantuotą rezultatą;
▪ Sutartį, įmokų planą.
✅ "SanLab" specialistai padės greitai ir nebrangiai panaikinti bet kokios rūšies pelėsį ir pašalinti jo atsiradimo priežastis visiems laikams.
"SANLAB" TEIKIAMOS PASLAUGOS:
▪ Pelėsio sporų koncentracijos patalpų ore nustatymas.
▪ Pelėsio atsiradimo priežasčių nustatymas.
▪ Rasos taško ir santykinės drėgmės matavimas sertifikuotais prietaisais.
▪ Pelėsio atsiradimo priežasčių šalinimas.
▪ Vizualiai matomo pelėsio šalinimas.
▪ Giluminis pelėsio naikinimas.
▪ Konsultacijos dėl pelėsio atsiradimo patalpose prevencijos.
▪ Patalpų ore esančio pelėsio bei pašalinių kvapų naikinimas specialiu ozonatoriumi bei jonizatoriumi.
✅Savo darbe naudojame tik EKOLOGIŠKUS metodus, produktus ir įrangą.
Mūsų įmonė bendradarbiauja su Nacionaline visuomenės sveikatos priežiūros laboratorija bei mikrobiologijos specialistais, kurie leidžia mums teikti aukštos kokybės klientų aptarnavimą ir nepriekaištingą mūsų darbo rezultatą.
Skambinkite dabar +37067053336
Kiti vartotojo skelbimai
 Patalpų ozonavimas
Patalpų ozonavimas
Patalpų veikimas ozono-oro mišiniu (Dezinfekavimas, kvapų šalinimas, oro valymas) PATALPŲ VEIKIMAS OZONO-ORO MIŠINIU LEIDŽIA VIENU METU ATLIKTI ŠIUOS DARBUS: - Dezinfekuoti patalpas; - Nustatyti...
1,00 € Vilnius Įkelta: 2021 06 08  Kvapų naikinimas
Kvapų naikinimas
BET KOKIOS KILMĖS KVAPŲ NAIKINIMAS - ORO DEZODORACIJA. Žinoma, kad daugelis kvapų yra ne tik nemalonūs, bet ir pavojingi sveikatai. Mūsų naudojamas ekologiškas ozonavimo metodas sunaikina bet kokio...
1,00 € Vilnius Įkelta: 2021 06 08  Alergenų naikinimas
Alergenų naikinimas
NAMŲ ŪKIO ALERGENŲ NAIKINIMAS Alergijos trukdo mūsų gyvenimui. Jos ne tik sukelia diskomfortą, rūpesčius, bet ir gali sukelti stiprią imuninės sistemos reakciją. Sergant alergija ar turint polinkį į...
1,00 € Vilnius Įkelta: 2021 06 08  Dezinfekcija
Dezinfekcija
ORO, PATALPŲ, ĮRANGOS IR PRODUKTŲ DEZINFEKAVIMAS Įprasti dezinfekavimo metodai dažnai būna neveiksmingi arba be galo brangūs. Šiuolaikinis dezinfekcijos ozonu metodas padidina efektyvumą ir leidžia...
1,00 € Vilnius Įkelta: 2021 06 08  Mini rekuperatoriai. Rekuperatorių montavimas
Mini rekuperatoriai. Rekuperatorių montavimas
MINI REKUPERATORIAI IR JŲ MONTAVIMAS Nuolatos savo bute atidarote langus norėdami įkvėpti gryno oro? Jaučiate nuovargį ir silpnumą? Namuose užsistovi nemolonūs kvapai ar atsiranda pelėsis? Visų...
1,00 € Vilnius Įkelta: 2021 06 08  Ekologinių pažeidimų patalpose tyrimai
Ekologinių pažeidimų patalpose tyrimai
EKOLOGINIŲ PAŽEIDIMŲ PATALPOSE KOMPLEKSINIAI TYRIMAI. Ekologinių rodiklių normų pažeidimas darbo ar namų patalpose gali labai pakenkti sveikatai, žymiai susilpninti imunitetą, sumažinti efektyvumą...
1,00 € Vilnius Įkelta: 2021 06 08  Ekologiškas valymas BioLife Cleaning
Ekologiškas valymas BioLife Cleaning
BioLife Cleaning - tai inovatyvi, unikali, saugi ir ekologiška patalpų valymo paslauga. PASIRINKDAMI BIO-LIFE CLEANING VALYMO PASLAUGĄ JŪS GAUNATE: ▪ visų paviršių sterilizavimą; ▪ patalpos oro d...
1,00 € Domina keitimas Vilnius Įkelta: 2021 06 08